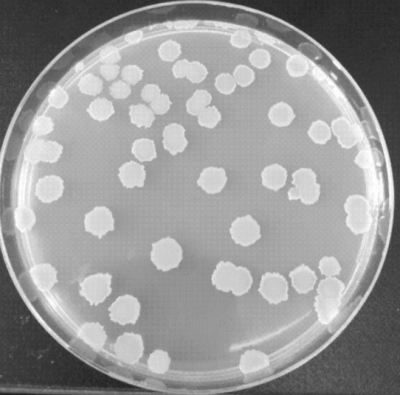

| 提交询价信息 |
| 发布紧急求购 |
价格:电议
所在地:北京
型号:
更新时间:2024-09-06
浏览次数:768
公司地址:北京市顺义区信中北街16号院3号楼4层432
![]()
李果(女士)
白囊耙齿菌
白囊耙齿菌(Irpex lacteus):担子纲一年生,平展至反卷,菌盖8-15×9-20mm,厚1.5-3mm,表面白色,有细长毛,菌管长1-2mm孔面白色或蛋黄白色,管口2个/mm,常裂为齿状·菌丝系统二体型生殖菌丝具简单隔膜,直径3-4μm,囊状体显著,被结晶30-50×6-8μm,担孢子圆柱形透明平滑,4.5-6×2.5-3μm,野生状态下寄生于油松(Pinus tabulaeformis)上。
菌种简介
平台编号:Bio-110814
规格:冻干粉/培养物
拉丁属名:Irpex Lacteus
菌株名称:白囊耙齿菌
用途:DSM原装进口
注意事项:仅用于科学研究或者工业应用等非医疗目的不可用于人类或动物的临床诊断或治疗,非药用,非食用(产品信息以出库为准)
详细描述
Name:Irpex lacteus Fries
DSM No.:1183
Other collection no.
or WDCM no.:
CBS 431.48, CCFC 9591, DAOM 8049
Isolated from:
Quercus sp.
Country:
Canada
o
Date of sampling:
before 22.08.1990
Nagoya Protocol Restrictions:
There are NO known Nagoya Protocol restrictions for this strain.
History:
<- K. Kieslich (Polyporus tulipiferae) <- CBS <- M.K. Nobles
Genbank accession numbers:
ITS rRNA gene: AY569565
Cultivation conditions:
Medium 90 , 24°C
Complete DSMZ Media List
Summary and
additio
<- K. Kieslich (Polyporus tulipiferae) <- CBS <- M.K. Nobles. Quercus sp.; Canada, Ontario. Sequence accession no. ITS rRNA gene: AY569565. (Medium 90, 24°C).
Risk group:
1 (classification according to German TRBA)
Supplied as:
Delivery form Prices
Price Category for this culture: 1
Freight and handling charges will be added. See price list.
Other cultures:
All DSMZ cultures of the species
Print data sheet
欢迎访问微生物菌种查询网,本站隶属于北京百欧博伟生物技术有限公司,单位现提供微生物菌种及其细胞等相关产品查询、咨询、订购、售后服务!与国内外多家研制单位,生物医药,第三方检测机构,科研院所有着良好稳定的长期合作关系!欢迎广大客户来询!
免责声明:以上所展示的[ 白囊耙齿菌]信息由会员[百欧博伟生物技术有限公司]自行提供,内容的真实性、准确性和合法性由发布会员负责。